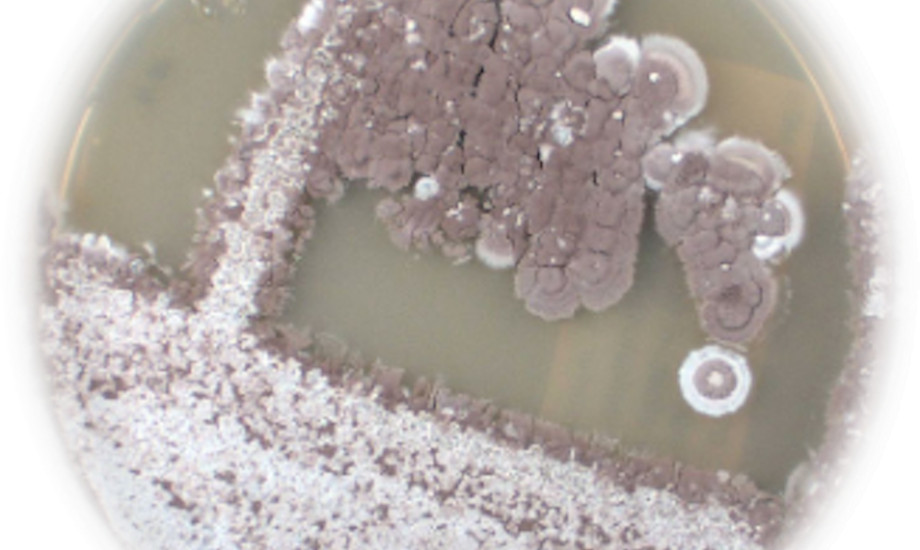

Neue Aktinomyceten-Stämme erhalten Frauennamen
Forscherinnen des Leibniz-Instituts DSMZ-Deutsche Sammlung von Mikroorganismen und Zellkulturen GmbH haben 28 Actinomyceten charakterisiert und auf ihr biotechnologisches Potenzial untersucht – dabei neu entdeckte biotechnologisch interessante Arten erhalten nun weibliche Namen.
© DSMZ
© DSMZ 


















